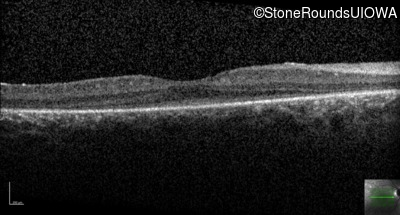
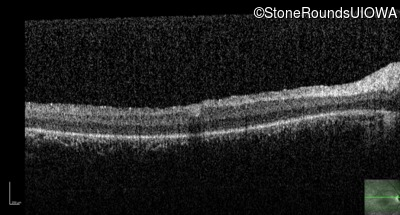
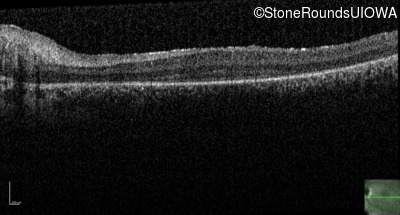
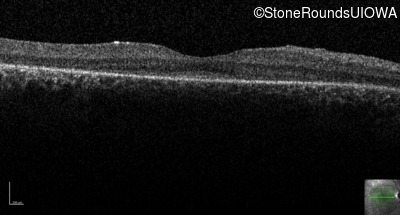
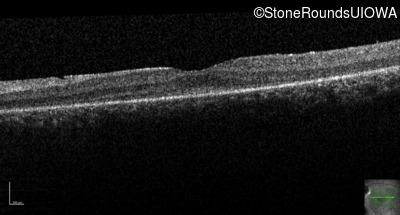
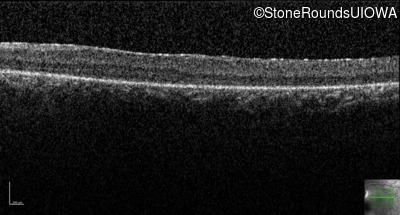
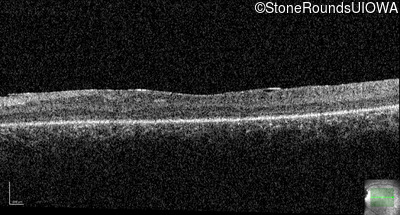
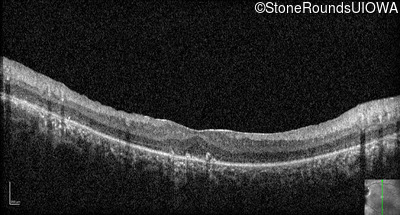
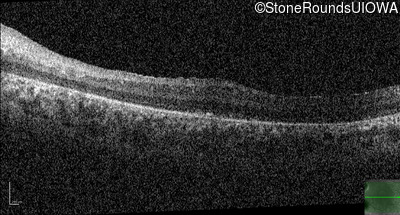

Case
SR281
Student Mode
Senior-Loken Syndrome (IB4)
Male
Male
Hidden
SR281
Student Mode
Senior-Loken Syndrome (IB4)
Male
Male
Highlighted Images
| Age at visit: 15 years | OD | OS |
|---|---|
History
This 15 year old male has had very poor vision and nystagmus since the first year of life.
| Age at visit: 12 years |
| OD | OS | ||
|---|---|---|---|
| OD | OS | ||
|---|---|---|---|
| Age at visit: 13 years |
| Age at visit: 15 years |
| Age at visit: 17 years |
| Age at visit: 19 years |
| Age at visit: 22 years |
| Age at visit: 24 years |
| Age at visit: 26 years |
Diagnosis & molecular findings
| Disease | Gene | Allele 1 variant(s) | Allele 2 variant(s) | Inheritance mode |
|---|---|---|---|---|
| Senior-Loken Syndrome | IQCB1 | Phe141 del2cacTT | Phe141 del2cacTT | AR |
Disease:
Gene:
Allele 1:
Phe141 del2cacTT
Allele 2:
Phe141 del2cacTT
Inheritance:
AR